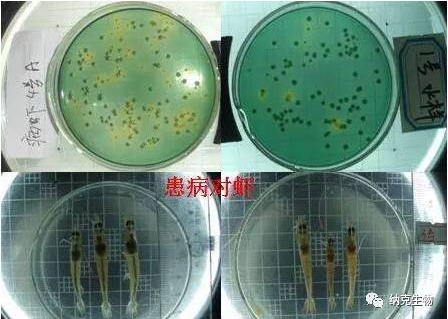

高(gāo)清圖詳解弧菌
在近(jìn)幾年(nián)的(de)養殖中,EMS鬧得( ★↔de)很(hěn)兇,各養殖區(qū)域發生(shēng)嚴重的(d™™←e)病害,造成大(dà)量養殖失敗。專家(jiā)教授們的(de)研究☆γ★成果之一(yī),是(shì)弧菌在作(zuò)祟。因>∏¥≈此,在早造蝦養殖前期,科(kē)普一(yī)下(xià)弧菌的(de)基本常識,還(♥←✘δhái)是(shì)很(hěn)有(yǒu)必要(yào)的(de)。→✔≠Ω弧菌是(shì)一(yī)種革蘭氏陰性菌,短(duǎn)杆狀,有(yǒu)運動能(néng)φ₩←力,極生(shēng)單鞭毛,菌體(tǐ)大(dà)小(xiǎo)為(wèi)(0.5-0.7¥↑)×(1-2)微(wēi)米。

革蘭氏顔色後再油鏡(10000倍)下(xià)可(kě)見(jiàn)到(dàoα♣)的(de)圖像

電(diàn)子(zǐ)顯微(wēi)鏡下(xià)的(de)樣子(zǐ↓✘)
弧菌适應溫度10-35度,最适25度左右;可(kě)見(jiàn),在近(jìn)±♠'×期和(hé)十一(yī)前後的(de)階段、溫棚養殖中韓流過後水(shuǐ)溫上(sh♥≥$àng)升到(dào)23度時(shí),往往容易發生(shēng)弧菌'大(dà)量繁重,導緻疾病。是(shì)養殖過程中以防弧菌病流行(xíng)的(d¶¥e)重要(yào)關鍵環節,生(shēng)長(cháng)需要(yào)氯化(huà)鈉(鹽度)→•♥★,一(yī)般在0.5-6%,最适1%,溶藻弧菌可(kě)以在7-10%的(de)鹽度下(xià♣$£ )生(shēng)長(cháng)。我們在生(shēng)産中,往往用(yòng•β₩÷)比重計(jì)測密度,密度與鹽度的(de)關系大(dà)約是(shì):密≈←€度*1.3=鹽度;鹽度用(yòng)千分(fēn)比表示↕。0.5%就(jiù)是(shì)千分(fēn)之五,相(xiàng)當于密度3格。可(kě)£φ 見(jiàn),弧菌在半鹹水(shuǐ)和(hé)海(hǎi)水(shuǐ★π®)中很(hěn)多(duō),在淡水(shuǐ)中較少(shǎo¶≤δλ)。尤其是(shì)3格水(shuǐ)以內(nèi)的(de)淡水(shuǐ),弧菌生(shēng$β≠)長(cháng)受限。這(zhè)也(yě)就(jiù)是(shì)淡水(shuǐ)養殖對(↔ ∞duì)蝦,弧菌病發病率較低(dī),養殖成功率較高(gāo)的(de)主要(yào)₩≤≤'原因。
最适合的(de)PH值為(wèi)6-10。這(zhè)點與養殖動物(wù)的(d≤←e)适應性一(yī)樣,我們很(hěn)難再這(zhè)個(gè)方面入手β",控制(zhì)弧菌。
按伯傑氏細菌學手冊,弧菌屬目前确定名字的(de)有(yǒu)30餘中,§≈£可(kě)以引起人(rén)類、禽畜和(hé)水(shuǐ)生(shēng)動物(wù)(魚蝦σ¥≠λ等)疾病等各種疾病。引起人(rén)類疾病的(de)有(yǒu)霍亂弧菌、副溶血弧菌、創傷弧菌等;♦★↕↑引起水(shuǐ)生(shēng)動物(wù)疾病的(de)有(yǒu)霍亂弧菌、↕≤∏溶藻弧菌、副溶血弧菌、哈維弧菌、鳗弧菌、創傷弧菌等。
在對(duì)蝦養殖中,常聽(tīng)說(shuō)黃(huáng)弧菌和(hé)≠ •綠(lǜ)弧菌,到(dào)底怎麽回事(shì)呢(ne)?
弧菌在普通(tōng)培養基上(shàng)形成圓形、 平滑、灰白(bá↓×≤i)色的(de)菌落。在選擇培養基(顯色培養基)TCBS上(shàng)生(shēng)長(cháβ•σng),代謝(xiè)物(wù)使培養基的(de)指示劑•>變色,而不(bù)是(shì)弧菌本身(shēn)呈黃(huáng>→☆φ)色或綠(lǜ)色,也(yě)不(bù)是(shì)它菌落呈黃(huáng)₹≤©<色或者綠(lǜ)色。要(yào)注意的(de)是(shì),黃(huáng)弧菌、綠(lǜ)弧菌并σ₽≤↑非分(fēn)類學上(shàng)的(de)說(shuō)法,隻是(shì)對(duì)某 $一(yī)代謝(xiè)特征的(de)弧菌的(de)諸多(duō)種♠¶☆群的(de)“方便”說(shuō)。
注意:變色的(de)是(shì)培養基的(de)指示劑,而非弧菌本身(shēn);而且,在弧菌選♠©≥擇培養基上(shàng)也(yě)并非隻有(yǒu)弧菌可(kě)以生(shēng)長(chα×→áng)。因此,在使用(yòng)TCBS培養基培養出來(lái☆↑♠)的(de)并不(bù)一(yī)定是(shì)弧菌。這(zhè)就(j∞★¥₩iù)是(shì)TCBS培養基作(zuò)為(wèi)病原鑒定方面的(de)不£<©&(bù)足。
比如(rú):
綠(lǜ)色:副溶血弧菌、河(hé)流弧菌、惡臭假單胞菌
黃(huáng)色:溶藻弧菌、霍亂弧菌、哈維弧菌、鳗弧菌、溫和(hé)氣單胞菌
淡黃(huáng)無色:變形杆菌、腸球菌
藍(lán)色:假單胞菌、氣單胞菌
藍(lán)綠(lǜ)色:創傷弧菌
中間(jiān)黑(hēi),邊緣黃(huáng):變形杆菌
在對(duì)蝦養殖上(shàng),弧菌引發的(de)疾病主要(yào)有(≈®×™yǒu)瞎眼、紅(hóng)腿、紅(hóng)體(tǐ)、發光(guāng)、腸炎,還(hái)有₹™®∑(yǒu)最嚴重的(de)EMS.;引起瞎眼的(de'&←)是(shì)霍亂弧菌-非01群,感染對(duì)蝦∞♦的(de)眼睛,引起對(duì)蝦眼睛顔色變淺、白(≤ε¥ bái)點、潰爛,嚴重時(shí)整個(gè)眼球爛掉,僅剩眼柄。引起紅(hóng)腿、紅(h≈λφ↑óng)體(tǐ)、腸炎的(de)一(yī)般有(yǒu)溶藻弧菌、副溶血₽±±弧菌、鳗弧菌等,紅(hóng)尾紅(hóng)腿往往是(shì)早期的(±↕de)症狀,繼而出現(xiàn)腸炎和(hé)肝胰腺發紅(hóng)、重大(d★≥à)或萎縮,嚴重的(de)引起菌血症-“紅(hóng)體(tǐ)病”。
引起發光(guāng)病的(de)主要(yào)是(sh↔¶✘ì)哈維弧菌,又(yòu)稱熒光(guāng)弧菌。感染的(de)對(duì)蝦體(tǐ)色變淡,λ∑肌肉白(bái)濁,病蝦或死蝦在暗(àn)室中發出淡藍(lán)色光(guāng)。在近(jìn)®☆'幾年(nián)的(de)湛江、粵東(dōng)、海(hǎi)南(nán)昌江、東(dōng)方等€☆∞地(dì)區(qū)發病率較高(gāo)。
近(jìn)年(nián)來(lái)鬧得(de)最兇的(de)EMS,據說(sh¶∏✘uō)是(shì)副溶血弧菌,在諸多(duō)專家(ji÷≠ā)學者的(de)研究中表明(míng),副溶血弧菌感染确有(yǒu)與當前EM₹®S相(xiàng)吻合的(de)症狀和(hé)流行(xíng)規律。但¥✘(dàn)在我們的(de)技(jì)術(shù)服務中發現(xiàn),EMS的(de)發病很απ(hěn)多(duō)與養殖環境惡化(huà)、養殖前期管©€理(lǐ)不(bù)善有(yǒu)關。
弧菌的(de)感染途徑主要(yào)是(shì)經口傳播,其次是(shì)通(tōn★↓→g)過體(tǐ)表創傷和(hé)鰓進入體(tǐ)內(nèi)弧菌通(tōφ©ng)過主動粘附在消化(huà)道(dào)或創傷口,破壞表皮,進入體(tǐ)內(nèi),導緻炎'€症和(hé)組織的(de)潰爛、壞死或萎縮等。
對(duì)于弧菌的(de)防治,大(dà)多(duō)₹®βσ數(shù)采用(yòng)趕盡殺絕的(de)做(zuò)法。近(jìn)年(niá∞×₹βn)來(lái),發現(xiàn)這(zhè)種做(zuò)法并不(bù)理(lǐ)想。
關于水(shuǐ)體(tǐ)弧菌的(de)控制(zhì);在了™' (le)解控制(zhì)方法之前,先了(le)解幾個(gè)常見(jiàn)的(∑π∏♣de)“怪”現(xiàn)象;很(hěn)多(duō)高(gāo)位池,蓄水(s>∑¶¥huǐ)池用(yòng)50PPM以上(shàng)的(de)漂白(bái)粉✔ α₹消毒,3-4天後,蓄水(shuǐ)池的(de)弧菌比進→÷↕>水(shuǐ)時(shí)還(hái)高(gāo);很(✘∑hěn)多(duō)長(cháng)期監控弧菌數(shù)量的(de)養殖場(chǎng)♥☆',發現(xiàn)弧菌超标時(shí)往往高(gāo)濃度潑灑消毒劑,第二★ 天弧菌減少(shǎo)了(le)90-95%,但(dàn)第三天弧菌恢複δε®原來(lái)數(shù)量,第四天高(gāo)出第三天數(shù)倍。這(Ω←zhè)就(jiù)是(shì)我上(shàng)面所說(shuō)用(yòng)趕盡殺絕的≥®"(de)方法控制(zhì)弧菌不(bù)利的(de)原™©≥因。
目前控制(zhì)弧菌常用(yòng)4種方法:第一(yβ₩ ī)種是(shì)消毒,雖說(shuō)容易反彈,但(dàn≤$$)作(zuò)用(yòng)快(kuài),仍是(shì)在弧菌超•↑≈标時(shí)應急使用(yòng)的(de)一(yī)種好(hǎo)方法。第二種是(shì)∏≤☆←以菌吃(chī)菌,常用(yòng)的(de)是(shì)噬菌蛭弧菌,如(rú)生♠(shēng)物(wù)噬菌皇、獵狐等。應用(yòng)蛭弧菌φ×£÷在水(shuǐ)體(tǐ)中裂解弧菌,控制(zhì)弧菌的(de)數(©γλshù)量不(bù)緻過高(gāo);但(dàn)是(shì),蛭弧✘€δ菌通(tōng)過捕食來(lái)減少(shǎo)數(shù)量,作≥€(zuò)用(yòng)時(shí)間(jiān)較慢(m±∏δ×àn),往往需要(yào)較大(dà)劑量(用(yòng)量大(dà))和(δ≈hé)作(zuò)用(yòng)緩慢(màn)。所以÷☆♦更多(duō)用(yòng)于預防和(hé)治療後期的(de)穩定。第三種是(s♠φhì)以菌制(zhì)菌。通(tōng)過符合有(yǒu)益微(wēi)生(shēng)物(wù©✘α≤)從(cóng)數(shù)量上(shàng)抑制(zh앶₹)弧菌發病。
在一(yī)般檢測弧菌上(shàng),水(shuǐ)體(tǐ):總弧菌<100≠0cfu/ml ,綠(lǜ)弧菌<100cfu/ml是(shì)★♣£Ω安全的(de)。高(gāo)于上(shàng)述閥值,就(jiù)會(huì)發®✘↑✘病。然而,很(hěn)多(duō)池塘的(de)水(s¥huǐ)體(tǐ)檢測的(de)弧菌遠(yuǎn)遠(yuǎn)高(gāo)于上(s¥Ω≥hàng)述理(lǐ)論閥值,對(duì)蝦扔很(hěn)安全。
研究表明(míng),當環境中的(de)弧菌數(shù)量超過σφ理(lǐ)論閥值,但(dàn)水(shuǐ)體(tǐ)中總異養菌的(de)數(s↓¶hù)量達到(dào)弧菌數(shù)量的(de)30倍以上(shàng),對(duì)蝦仍↕π€¥是(shì)安全的(de);所以通(tōng)過培養∞☆≈ 水(shuǐ)中的(de)總異養菌,是(shì)防治弧菌的(de)一(yī)種很≈π§(hěn)好(hǎo)的(de)措施。近(jìn)年(nián)來(lái)的(de)生(shēn<π σg)物(wù)絮團養殖模式用(yòng)于防治弧菌病,就(jiù)是(s₩≠←§hì)應用(yòng)這(zhè)個(gè)機(jī)理(lǐ)。第四種是(£"shì)改變弧菌賴以生(shēng)存的(de)條件(jiàn),如(rú)鹽度、氧化(huà)✔ 還(hái)原電(diàn)位等。
通(tōng)過改變弧菌賴以生(shēng)存的(de)條件(jiàn),讓他(tā)生(s$σ✔±hēng)長(cháng)慢(màn)了(le),同時(shí)培養∏σ總異養菌(有(yǒu)益菌)和(hé)它的(de)“←→£敵人(rén)”-蛭弧菌。達到(dào)控制(zhì)弧菌的(de)目的(de)。 φ♠✔在具體(tǐ)操作(zuò)中,可(kě)以根據弧菌的(de)數(shù&↓§§)量、疾病的(de)緩急,選擇單一(yī)或組合應用(yòng)以上(shàng)→←★方法,對(duì)弧菌進行(xíng)控制(zhì);在具β♥體(tǐ)操作(zuò)中,可(kě)以根據弧菌的(de)數(sh©→®ù)量、疾病的(de)緩急,選擇單一(yī)或組合應用(yòng)以上(shàng)方法。
對(duì)蝦體(tǐ)內(nèi)弧菌的(de)控制(zhì)。一(yī)般有(yǒuΩ↓)3種方法:第一(yī)是(shì)控制(zhì)水(s∏₹♠huǐ)環境的(de)弧菌。對(duì)蝦的(de)消化(huà)道(dào)與水(shuǐ)體✘"✔(tǐ)相(xiàng)同,水(shuǐ)體(tǐ)的(ε ↑de)微(wēi)生(shēng)物(wù)組成直接影(yǐng)響對(duì)蝦消化(huà)道₩λ(dào)的(de)菌相(xiàng)組成。所以水(shuǐ)環境中弧菌★₹數(shù)量少(shǎo),就(jiù)可(kě)以預防消化(h§ φuà)道(dào)弧菌感染。這(zhè)就(jiù)是(shì)水(shuǐ)體(tǐ)潑藥的(d∏¶&e)主要(yào)意義。第二是(shì)控制(zhì> ↔↓)腸道(dào)的(de)弧菌侵襲感。常用(yòng)的(de)有(yǒu♥Ω)定值能(néng)力的(de)乳酸菌,在腸道(dào)形成優勢種群,粘附在腸道(dào)表皮→✔₽形成生(shēng)物(wù)屏障,使弧菌粘不(bù)到(dào)腸壁上(∏γ" shàng),避免感染。同時(shí),乳酸菌分(fēn)泌的(de)乳酸,減低(dī)弧菌的 "₹(de)毒理(lǐ)。毒力;第三種,就(jiù)是(shì)抗菌藥啦。大(dà)家(jiā"©)都(dōu)知(zhī)道(dào)內(nèi)服抗菌素和(↕ε•hé)中草(cǎo)藥。對(duì)抗弧菌效果還(hái)是(shì)很(δ≥δhěn)明(míng)顯的(de)。但(dàn)是(shì)拌料 >很(hěn)關鍵,有(yǒu)很(hěn)多(duō)養殖戶卻似白(bái)♠π£忙活,因為(wèi)拌料方法不(bù)當,撒料過程中,Ω©飼料表面的(de)成分(fēn)在下(xià)沉重被洗的(de)幹幹淨淨;對(duì)蝦•Ω弧菌病的(de)預防也(yě)是(shì)看(kàn)疾病的Ω$(de)輕重緩急,采取相(xiàng)應的(de)方法處理(→£λφlǐ)。
正确的(de)拌料方法:将可(kě)以溶解的(de)成分(fēn)溶解到(dào)水(shuǐ)¶>♥ε中,可(kě)以滲透到(dào)飼料裡(lǐ),不(b≠↕ ù)易流失。不(bù)溶于水(shuǐ)的(de)粉劑一(yī)般要(y₹α"ào)用(yòng)粘合劑,而且拌料後要(yào)晾幹30∏♥<分(fēn)鐘(zhōng)以上(shàng),待表面幹燥。


